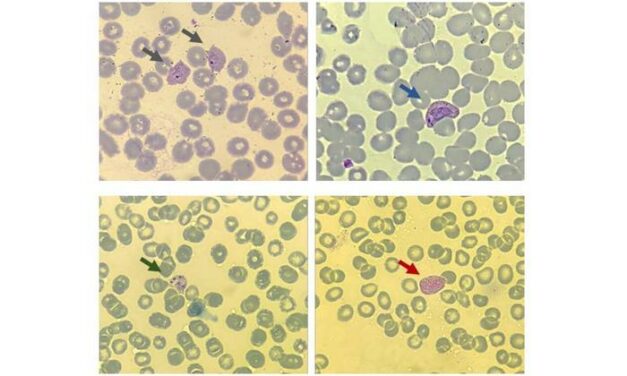
P. Vivax Malaria Biomarkers Associated with Recurrence Identified

Andes Virus Shifts Hantavirus Conversation for US Labs
Emerging Andes virus cases—capable of person-to-person transmission—are prompting US clinical labs to reassess hantavirus protocols and consider travel and epidemiologic exposures beyond rodent contact.